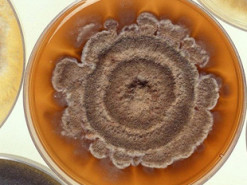
Бактерия-компьютер: как цифровые идеи создают новую биологию

...
...
Немецкий поставщик автомобильных компонентов Bosch объявил, что разработал датчик, который позволяет автомобилям «видеть» трехмерное изображение на дороге. Он также снизит стоимость технологии, которая ускорит разработку автономных транспортных средств, сообщает Reuters.